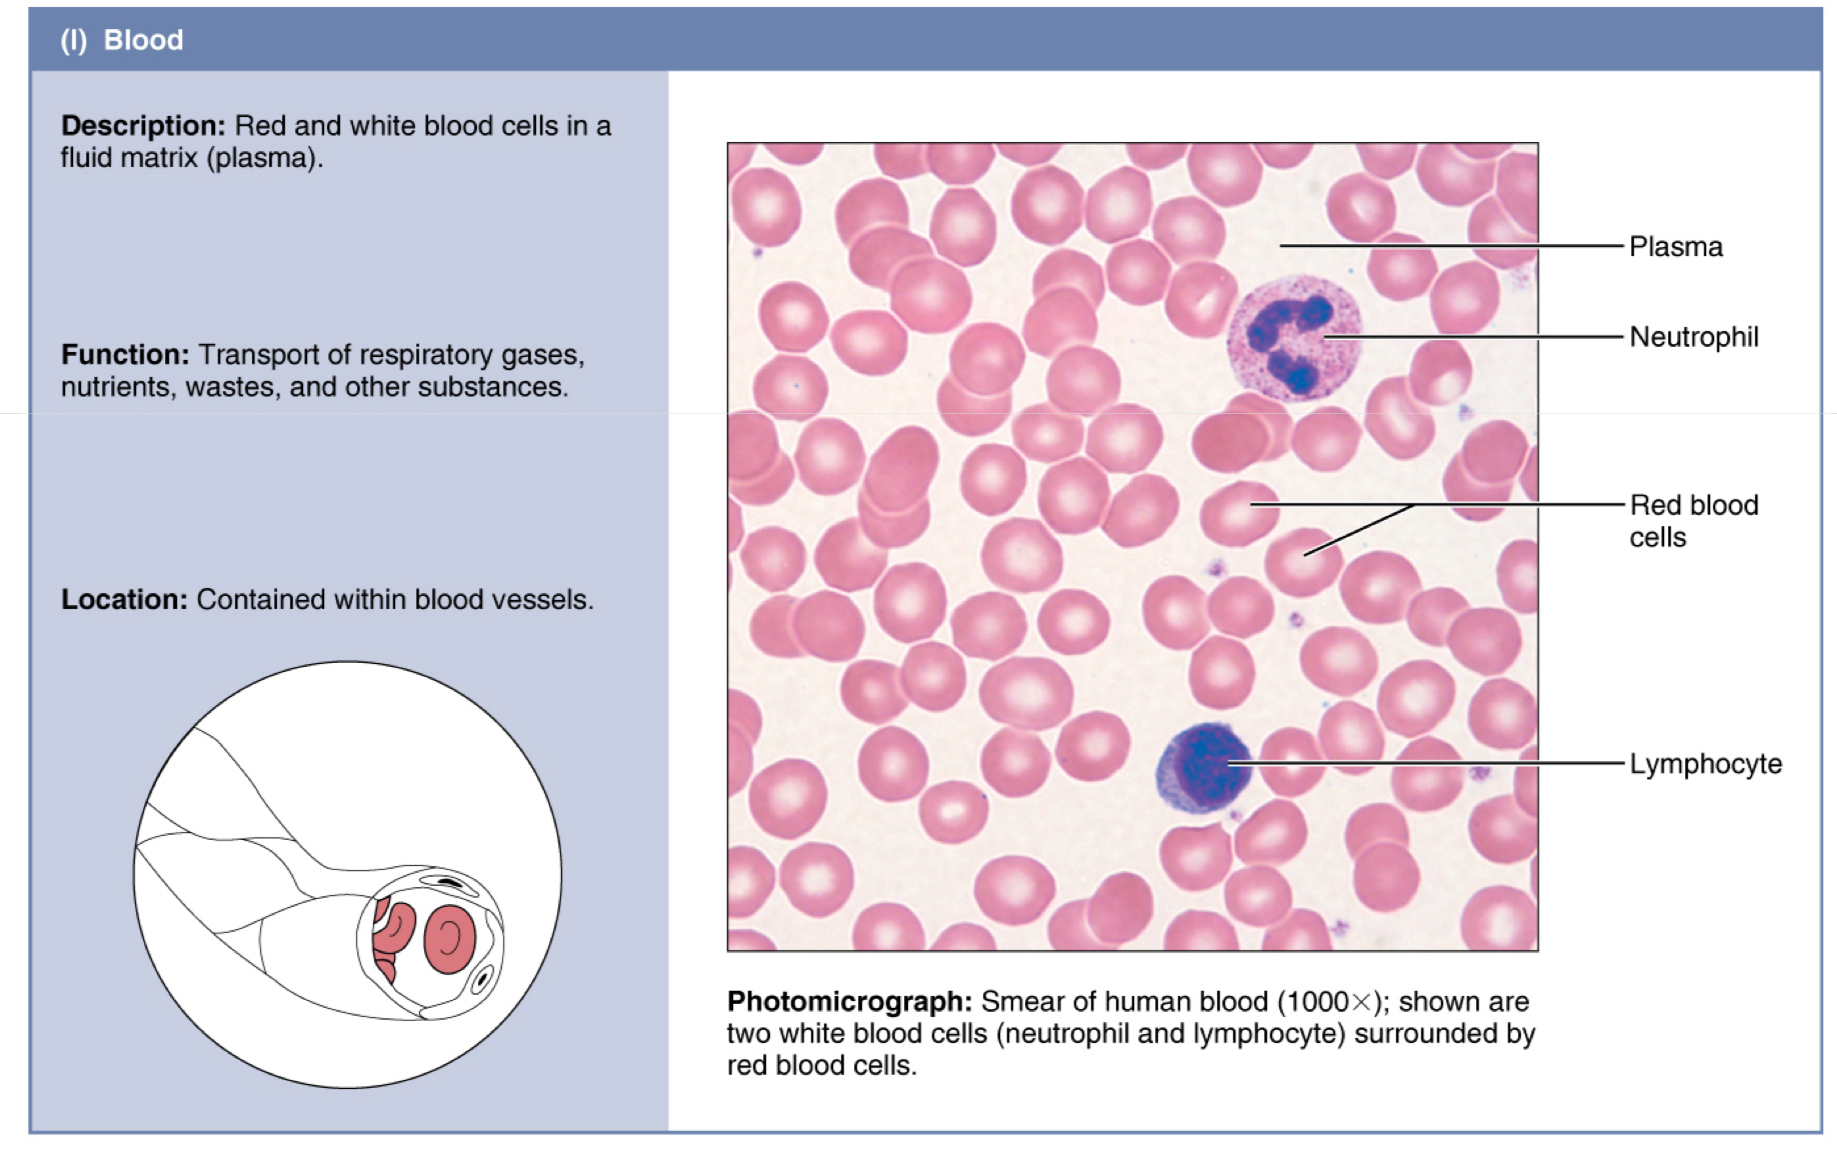
<p>Sangre</p>

1/10
Looks like no tags are added yet.
Name | Mastery | Learn | Test | Matching | Spaced | Call with Kai |
|---|
No analytics yet
Send a link to your students to track their progress

Areolar
Parte de la membrana basal, mesenterios

Adiposo
hipodermis, tejido mamario

Reticular
Bazo

Denso regular
tendones, ligamentos

Cartílago elástico
oreja, epiglotis

denso irregular
dermis

Cartílago Hialino
cartílago articular, tráquea

cartílago elastico
oreja, epiglotis

cartílago fibroso
discos intervertebrales, meniscos

hueso compacto
esqueleto
Sangre
dentro del corazón y vasos sanguíneos